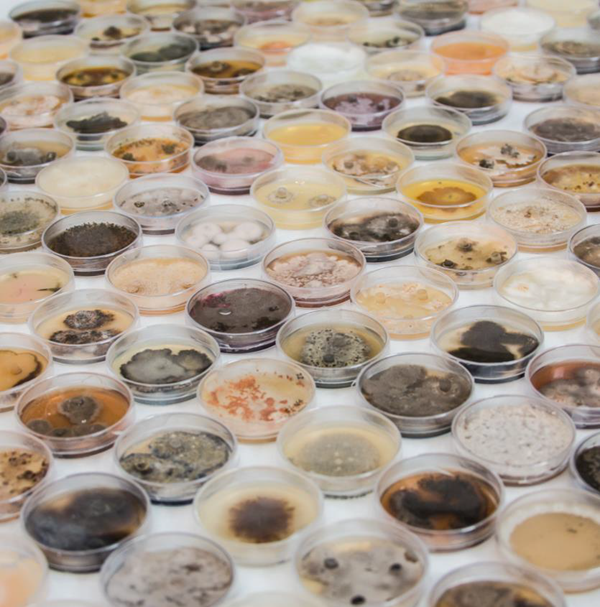
Expanding discovery with chemical diversity in natural product libraries

This article is based on a poster originally authored by José R. Tormo, Arnau Comajuncosa-Creus, Teresa Sardón, Germán Martínez, Fernando Reyes, Patrick Aloy and Olga Genilloud, which was presented at ELRIG Drug Discovery 2024 in affiliation with Fundación MEDINA and Institute for Research in Biomedicine (IRB).
This poster is being hosted on this website in its raw form, without modifications. It has not undergone peer review but has been reviewed to meet AZoNetwork's editorial quality standards. The information contained is for informational purposes only and should not be considered validated by independent peer assessment.

Introduction
Natural Product (NP) libraries have been successfully used as a source of bioactive molecules, offering a vast array of chemical structures for Drug Discovery in the past. Although its utilization has diminished compared to the prominence of synthetic libraries, the chemical space covered by these two types of libraries may differ.
Image Credit: Image courtesy of José R. Tormo et al., in partnership with ELRIG (UK) Ltd.
Overview
- GOAL: To compare the chemical diversity of compounds isolated from MEDINA´s NP Library with those from different libraries representing synthetic and natural small molecule collections.
- METHODOLOGY: Bioactivity signatures from the tool ChemicalChecker encoded small molecules' physicochemical and structural properties. Descriptors were then plotted in two-dimensional representations (t-SNE) for visual comparison.
MEDINA´s NP library vs other libraries

Image Credit: Image courtesy of José R. Tormo et al., in partnership with ELRIG (UK) Ltd.

Image Credit: Image courtesy of José R. Tormo et al., in partnership with ELRIG (UK) Ltd.
Metabo Lights: Global database (DB) for metabolomics studies including raw experimental data and the associated metadata. This DB is cross-species and cross-technique and covers metabolite structures and their reference spectra as well as their biological roles and locations where available 1.
Collective Molecular Activities of Useful Plants (CMAUP): Collective molecular activities of 7,865 useful plants, including 2,954 medicinal plants used in 79 countries/regions, on 758 human target proteins and 3,013 Gene Ontology, 238 KEGG pathways, and their relations to 1,399 human diseases.2
IRB: 50,000 compounds from the ChemDiv library, representing over 1,500,000 compounds. Including focused subsets such as protein-protein interaction (PPI), CNS, cancer, diverse sets, and lead-like sets, among others.3
The Drug Repurposing Hub: Curated and annotated collection of FDA-approved drugs, clinical trial drugs, and pre-clinical tool compounds with a companion information resource.4
Chemical Checker: Compound database with processed, harmonized, and integrated bioactivity data on ~1,000,000 small molecules.5
Methods and results
1. Compounds have been standardized and converted to International Chemical Identifier (InChI).

Image Credit: Image courtesy of José R. Tormo et al., in partnership with ELRIG (UK) Ltd.
2. Different physicochemical and structural features of the studied compounds were encoded into descriptors using the Chemical Checker Signaturizer tool.3,5

Image Credit: Image courtesy of José R. Tormo et al., in partnership with ELRIG (UK) Ltd.
3. The generated physicochemical and structural descriptors were visually compared by means of t-SNE representations.3,5

Image Credit: Image courtesy of José R. Tormo et al., in partnership with ELRIG (UK) Ltd.
SMILE information from 1,751 compounds isolated from MEDINA´s library and identified by MS/NMR, and SMILES from compounds included in the other studied libraries were first standardized and converted to InChI (Fig 1). A small negligible overlap between the MEDINA compounds and the other libraries was observed (Fig. 1).
To perform the structural comparisons, we used bioactivity signatures from the Chemical Checker,3,5, which encode small molecules' physicochemical and structural properties. Comparing the characteristics of the input compounds with the tool training dataset confirmed this tool's applicability to the different compound libraries (Fig. 2).
The obtained compound descriptors were then plotted in two-dimensional representations (t-SNE) for a visual comparison. Specifically, we used the A1-5 spaces of the Chemical Checker to complete the chemical description of the small molecules compared: 2D fingerprints (A1), 3D fingerprints (A2), Scaffolds dispersion (A3), structural Key features (A4), and physicochemical properties (A5) (Fig. 3).
Conclusions
- MEDINA´s Library virtually covers all the chemical diversity of known Natural Products.
- NP and Synthetic Compound Libraries occupy different diverse regions of the chemical space, which are complementary.
- Combining natural products and synthetic compounds expands the chemical diversity of the resulting library and increases the search space for any drug discovery program.

Image Credit: Image courtesy of José R. Tormo et al., in partnership with ELRIG (UK) Ltd.
References
- Ozgur Yurekten, Payne, T., et al. (2023). MetaboLights: open data repository for metabolomics. Nucleic acids research, [online] 52(D1), pp.D640–D646. https://doi.org/10.1093/nar/gkad1045.
- Hou, D., et al. (2023). CMAUP database update 2024: extended functional and association information of useful plants for biomedical research. Nucleic Acids Research, 52(D1), pp.D1508–D1518. https://doi.org/10.1093/nar/gkad921.
- Duran-Frigola, M., et al. (2020). Extending the small-molecule similarity principle to all levels of biology with the Chemical Checker. Nature Biotechnology, [online] 38(9), pp.1087–1096. https://doi.org/10.1038/s41587-020-0502-7.
- Corsello, S.M., et al. (2017). The Drug Repurposing Hub: a next-generation drug library and information resource. Nature Medicine, [online] 23(4), pp.405–408. https://doi.org/10.1038/nm.4306.
- Bertoni, M., et al. (2021). Bioactivity descriptors for uncharacterized chemical compounds. Nature Communications, [online] 12(1), p.3932. https://doi.org/10.1038/s41467-021-24150-4.
About Fundación MEDINA
Fundación MEDINA's mission is the discovery of biologically active molecules, drug candidates for unmet medical needs, and products of high biotechnological value for the industry.
About ELRIG (UK) Ltd.
The European Laboratory Research & Innovation Group (ELRIG) is a leading European not-for-profit organization that exists to provide outstanding scientific content to the life science community. The foundation of the organization is based on the use and application of automation, robotics and instrumentation in life science laboratories, but over time, we have evolved to respond to the needs of biopharma by developing scientific programmes that focus on cutting-edge research areas that have the potential to revolutionize drug discovery.
Comprised of a global community of over 12,000 life science professionals, participating in our events, whether it be at one of our scientific conferences or one of our networking meetings, will enable any of our community to exchange information, within disciplines and across academic and biopharmaceutical organizations, on an open access basis, as all our events are free-of-charge to attend!
Our values
Our values are to always ensure the highest quality of content and that content will be made readily accessible to all, and that we will always be an inclusive organization, serving a diverse scientific network. In addition, ELRIG will always be a volunteer led organization, run by and for the life sciences community, on a not-for-profit basis.
Our purpose
ELRIG is a company whose purpose is to bring the life science and drug discovery communities together to learn, share, connect, innovate and collaborate, on an open access basis. We achieve this through the provision of world class conferences, networking events, webinars and digital content.
Sponsored Content Policy: News-Medical.net publishes articles and related content that may be derived from sources where we have existing commercial relationships, provided such content adds value to the core editorial ethos of News-Medical.Net which is to educate and inform site visitors interested in medical research, science, medical devices and treatments.
Last Updated: Nov 18, 2024